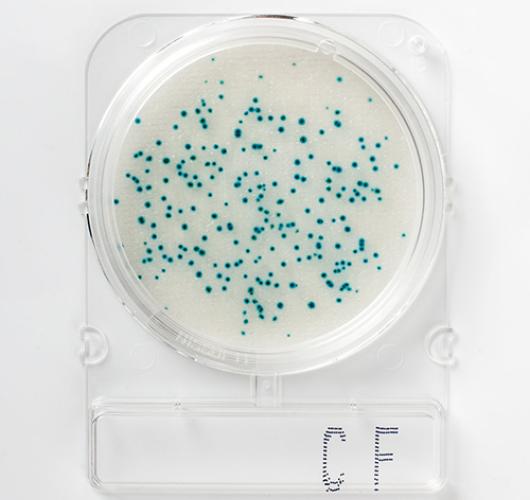
Подложки колиформные и фекальные колиформные бактерии - Compact Dry CF
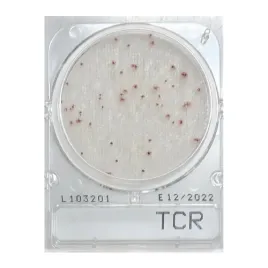

Подложки колиформные и фекальные колиформные бактерии - Compact Dry CF
Подложки колиформные и фекальные колиформные бактерии - Compact Dry CF
Готовая к использованию сухая хромогенная среда для идентификации бактерий колиформной группы.
Благодаря хромогенным субстратам/окислительно-восстановительным индикаторам микроорганизмы развиваются в определенных цветах, а подсчет колоний осуществляется очень четко. Это сводит к минимуму ошибки персонала, обеспечивая стандартизацию посадки. Она подходит для использования на всех этапах производства и экологического анализа.
Цвет колоний: E.coli: Синий – Зеленый
Температура и время инкубации:
Колиформы: 35–37°C / 18–24 часа
Фекальные колиформы: 40–42°C / 18–24 часа
Срок годности: 12–18 месяцев / 5–30°C